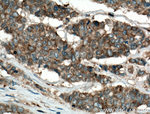
IQGAP1 Antibody in Immunohistochemistry (Paraffin) (IHC (P))

Search
Proteintech
IQGAP1 Polyclonal Antibody
{{$productOrderCtrl.translations['antibody.pdp.commerceCard.promotion.promotions']}}
{{$productOrderCtrl.translations['antibody.pdp.commerceCard.promotion.viewpromo']}}
{{$productOrderCtrl.translations['antibody.pdp.commerceCard.promotion.promocode']}}: {{promo.promoCode}} {{promo.promoTitle}} {{promo.promoDescription}}. {{$productOrderCtrl.translations['antibody.pdp.commerceCard.promotion.learnmore']}}
产品信息
22167-1-AP
种属反应
已发表种属
宿主/亚型
分类
类型
抗原
偶联物
形式
浓度
规格
纯化类型
保存液
内含物
保存条件
运输条件
产品详细信息
Immunogen sequence: QLSSSVTGL TNIEEENCQR YLDELMKLKA QAHAENNEFI TWNDIQACVD HVNLVVQEEH ERILAIGLIN EALDEGDAQK TLQALQIPAA KLEGVLAEVA QHYQDTLIRA KREKAQEIQD ESAVLWLDEI QGGIWQSNKD TQEAQKFALG IFAINEAVES GDVGKTLSAL RSPDVGLYGV IPECGETYHS DLAEAKKKKL AVGDNNSKWV KHWVKGGYYY YHNLETQEGG WDEPPNFVQN SMQLSREEIQ SSISGVTAAY NREQLWLANE GLITRLQARC RGYLVRQEFR SRMNFLKKQI PAITCIQSQW RGYKQKKAYQ DRLAYLRSHK DEVVKIQSLA RMHQARKRYR D (478-827 aa encoded by BC151834)
靶标信息
This gene encodes a member of the IQGAP family. The protein contains four IQ domains, one calponin homology domain, one Ras-GAP domain and one WW domain. It interacts with components of the cytoskeleton, with cell adhesion molecules, and with several signaling molecules to regulate cell morphology and motility. Expression of the protein is upregulated by gene amplification in two gastric cancer cell lines.
仅用于科研。不用于诊断过程。未经明确授权不得转售。
生物信息学
蛋白别名: Cdc42-Rac1 effector protein; DISP2; DISPB; KIAA0051; p195; Ras GTPase-activating-like protein IQGAP1; RasGAP-like with IQ motifs; unnamed protein product
基因别名: AA682088; D7Ertd237e; D7Ertd257e; HUMORFA01; IQGAP1; KIAA0051; mKIAA0051; p195; SAR1
UniProt ID: (Human) P46940, (Mouse) Q9JKF1
Entrez Gene ID: (Human) 8826, (Mouse) 29875